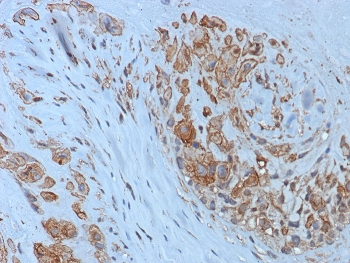
HLA-G Antibody

You have no items in your shopping cart.
Search results for: 'antibody'
IHC-P
Human
Rabbit
Recombinant
Unconjugated
100 μg, 20 μg- CA8 Antibody / Carbonic Anhydrase VIII [orb1822884]
WB
Human
Mouse
Recombinant
Unconjugated
100 μg, 20 μg - SF-1 Antibody / Steroidogenic Factor 1 / NR5A1 [orb1822697]
IHC-P
Human
Rabbit
Recombinant
Unconjugated
100 μg - SF-1 Antibody / Steroidogenic Factor 1 / NR5A1 [orb1822698]
IHC-P
Human
Rabbit
Recombinant
Unconjugated
100 μg, 20 μg